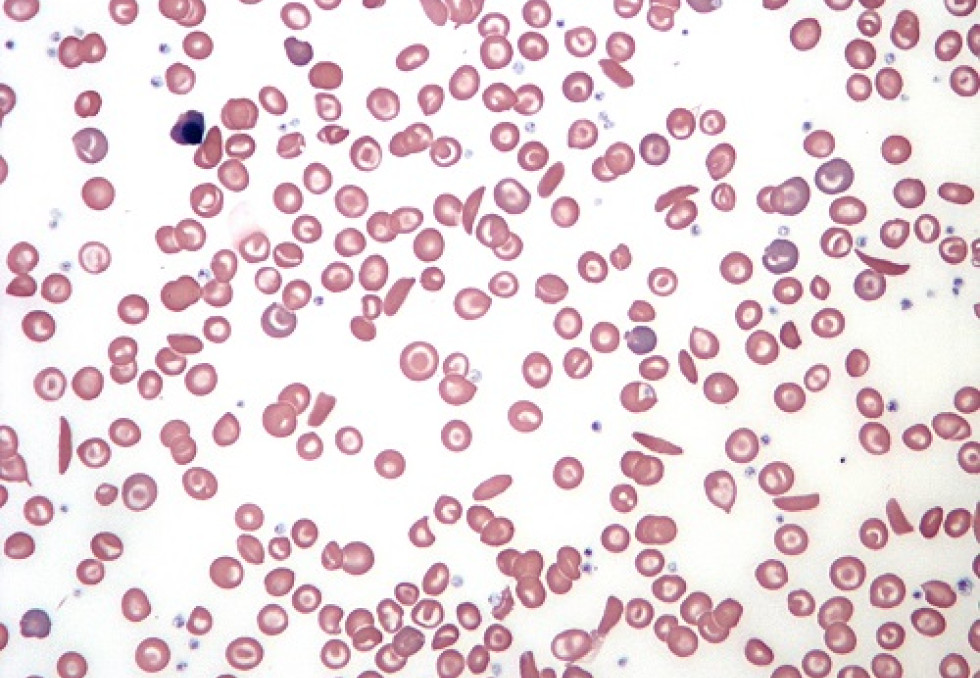

Drépanocytose : la HAS recommande le dépistage généralisé à la naissance
Or de nouvelles données épidémiologiques ont mis en évidence l’intérêt de cette nouvelle mesure. Ainsi, parmi les maladies dépistées à la naissance, la drépanocytose est la maladie génétique la plus fréquente. Et "c’est la seule maladie dépistée à la naissance dont l’incidence augmente régulièrement : 557 cas ont été dépistés en 2020 contre 412 en 2010", souligne la HAS. Son incidence progresse régulièrement : elle a atteint 1 nouveau-né sur 1323 en 2020.
Le dépistage, tel qu’il est pratiqué actuellement, est très hétérogène sur le territoire, particulièrement centré en Ile-de-France, où plus de trois enfants sur quatre en bénéficient, contre à peine un sur deux à l’échelle nationale en 2020. Pour la HAS, le ciblage actuel n’est pas suffisant et comporte un risque d’erreur, avec à la clé, un risque de "perte de chance élevée pour ces enfants" dont la maladie peut avoir de lourdes conséquences. "La drépanocytose est, par exemple, la première cause d’accident vasculaire cérébral chez l’enfant, rappelle la HAS. Sans prise en charge précoce, le taux de mortalité infantile chez les enfants atteints de drépanocytose est très élevé." Le diagnostic précoce permet, en particulier, de procéder aux vaccinations qui limitent le risque infectieux, première cause de décès chez ces enfants.
Une prise en charge précoce est ainsi nécessaire ; et le dépistage précoce est donc "indispensable", juge la HAS.
En outre, tous les éléments pratiques sont présents pour un dépistage efficace et sûr : test "très performant" (aucun faux-positif signalé en 20 ans), facilité d’utilisation (même support [test de Guthrie] que les autres tests néonataux). La HAS précise que "les acteurs consultés sont unanimes sur l’intérêt d’élargir le dépistage de la drépanocytose à tous les nouveau-nés. Ils n’ont pas remis en cause la capacité d’adaptation du système de santé à l’augmentation du flux de tests de dépistage. Sur le plan éthique, ils ont souligné que la généralisation du dépistage remédiait au risque de stigmatisation des populations actuellement ciblées par le dépistage actuel".
La sélection de la rédaction

Faut-il restreindre les conditions d'accès au secteur 2?
Herve Koskas
Non
Nous restons dans le gre à grè. L information doit etre claire: pas de surprise ; pas de dessous de table; c'est le but du S2 !. ... Lire plus